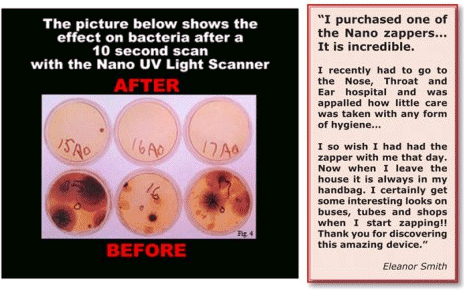
Nano BS

|
Nano Things and Giga Nonsense |
 |
When "nanotechnology" came into its own around, roughly, 2000, microelectronic people (like me) were a bit puzzled since according to the craze, we were doing
nanotechnology all along without noticing that. A lot of chemists were also puzzled; they came up with a joke: Do you know
a synonym for nanotechnology with 9 letters? (Solution: "Chemistry"). |
|
 |
Well, every now and then you need new words and visions to coerce politicians
and other obstacles to science to give you more money. "Nano" worked admirably and even produced all kinds of
real and imagined nanoproblems (that need to be solved; just give us money). |
 |
Whenever something like that happens in science, all kinds of other trades in
need of increasing revenue jump on the bandwagon; below are some examples. |
| | |
|
|
|
 |
| Don't you love the Turkish "Nano Keratin" (the stuff hair consists of)? |
|
| | |
|
|
|
 |
The "nanoflon" pan, far better , of course, than the
regular teflon-coated pan. |
| Source: Old "Quelle" catalogue |
|
| | |
|
| |
|
 |
| No comment |
| Source: http://markwiddicombe.wordpress.com/ |
|
| | |
|
 |
If you consider those pictures to be crazy or funny, what about the worlds smallest
"nano" solar cell? It's hard to believe but there was a serious competition for that asinine achievement among
scientists! |
| |
|
© H. Föll (Iron, Steel and Swords script)